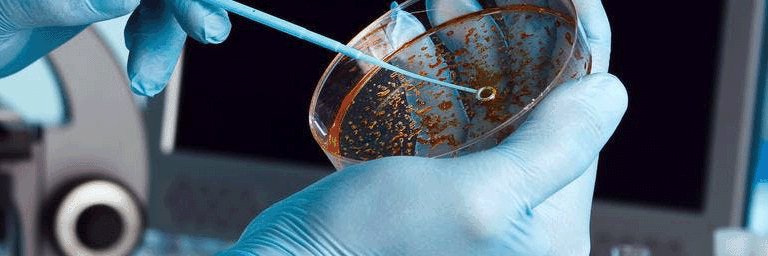
Impam banner

Impam
489 posts


Impam
@instituto_impam
Instituto de Investigaciones en Microbiología y Parasitología Médica
Buenos Aires Katılım Temmuz 2019
68 Takip Edilen73 Takipçiler
Impam
489 posts

@instituto_impam
Instituto de Investigaciones en Microbiología y Parasitología Médica